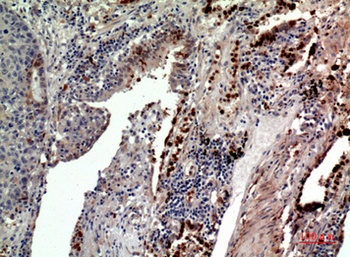
CD163b rabbit pAb Antibody

You have no items in your shopping cart.
CD163 antibody
Description
Images & Validation
−| Tested Applications | ICC, IF, IHC-P, WB |
|---|---|
| Dilution Range | IHC-P: 1: 100-600, WB: 1:500, ICC: 1:100 |
Key Properties
−| Host | Rabbit |
|---|---|
| Clonality | Polyclonal |
| Isotype | IgG |
| Immunogen | KLH conjugated synthetic peptide derived from human CD163. Please contact us for the exact immunogen sequence. The peptide is available as orb374759. |
| Target | CD163 |
| Molecular Weight | 125 kDa |
| Purity | Polyclonal antibodies are purified by peptide affinity chromatography |
| Conjugation | Unconjugated |
Storage & Handling
−| Storage | Maintain refrigerated at 2-8°C for up to 2 weeks. For long term storage store at -20°C in small aliquots to prevent freeze-thaw cycles. |
|---|---|
| Form/Appearance | 10 mM PBS, 0.02% sodium azide |
| Concentration | - 100 μg (in 200 μl): 0.5 mg/ml- 200 μg (in 400 μl): 0.5 mg/ml |
| Expiration Date | 12 months from date of receipt. |
| Disclaimer | For research use only |
Alternative Names
−Similar Products
−CD163 Recombinant Rabbit Monoclonal Antibody [orb612214]
IF, IHC-Fr, IHC-P, WB
Mouse, Rat
Human, Mouse, Rat
Rabbit
Recombinant
Unconjugated
25 μl, 50 μl, 100 μlCD163 Rabbit Polyclonal Antibody [orb182468]
IF, IHC-Fr, IHC-P, WB
Canine, Equine, Porcine, Rat
Human, Mouse, Rat
Rabbit
Polyclonal
Unconjugated
50 μl, 100 μl, 200 μlCD163b rabbit pAb Antibody [orb767011]
ELISA, IF, IHC, WB
Human, Mouse, Rat
Polyclonal
Unconjugated
100 μl

Quality Guarantee
Explore bioreagents carefree to elevate your research. All our products are rigorously tested for performance. If a product does not perform as described on its datasheet, our scientific support team will provide expert troubleshooting, a prompt replacement, or a refund. For full details, please see our Terms & Conditions and Buying Guide. Contact us at [email protected].

Immunohistochemical staining of paraffin embedded mouse skin tissue using CD163 antibody (primary antibody at 1:200)

WB analysis of human breast cancer (Lane 1), breast cancer (Lane 2), breast cancer (Lane 3) using anti-CD163 (dilution at 1:500)

Immunofluorescence image of rat skin tissue using anti-CD163 (dilution at 1:100)

IHC-P staining of pig lung tissue using anti-CD163 (dilution at 1:200)

Immunohistochemical staining of pig large intestines tissue using anti-CD163 (dilution of primary antibody - 1:200)

WB analysis of human breast cancel 25 (Lane1), breast cancel 24 (Lane2) using CD163 antibody (dilution at 1:100)

IHC-P image of human thyroid carcinoma tissue using CD163 antibody (dilution of primary antibody at 1:500)

IHC-P of human lung adenocarcinoma tissue using CD163 antibody (Dilution of primary antibody 1:200)

Western blot analysis of human cell lysates using CD163 antibody (please check application notes for details)

Immunohistochemical staining of paraffin embedded human colon cancer tissue (orb13303 at 1:200) using CD163 antibody. (Dilution of primary antibody 1:200)

Immunohistochemical staining of human colon cancer tissue using CD163 antibody. (Dilution of primary antibody 1:200)

Immunohistochemical staining of paraffin embedded mouse liver tissue using CD163 antibody. (Dilution of primary antibody 1:200)

IF analysis of mouse skin tissue using CD163 antibody (Dilution of primary antibody 1:100)

Immunofluorescent image of mouse liver tissue using CD163 antibody (Primary antibody at 1:100)

Immunohistochemical staining of mouse liver tissue using anti-CD163 (dilution of primary antibody - 1:200)

Immunofluorescent analysis of mouse lung tissue using CD163 antibody (Primary antibody diluted to 1:100)

Immunohistochemical staining of mouse skin tissue using CD163 antibody (dilution of primary antibody - 1:200)

Western blot analysis of guniea pig lymph (lane 1), rat brain (lane 2), mouse stomach (lane3), rat rectum (lane4), human gallbladder (lane 5), human lung cancer (lane 6) tissue using anti-CD163 (0.5 ug/ml)

IHC-P image of rat lymph tissue using anti-CD163 (2.5 ug/ml)

Immunohistochemical staining of rat lymph tissue using CD163 antibody (2.5 ug/ml)

Immunohistochemical staining of mouse stomach tissue using anti-CD163 (2.5 ug/ml)

IHC-P image of mouse stomach tissue using anti-CD163 (2.5 ug/ml)

Immunohistochemical staining of guinea pig colon tissue using anti-CD163 (2.5 ug/ml)

Immunohistochemical staining of guinea pig colon tissue using anti-CD163 (2.5 ug/ml)

Immunohistochemical staining of paraffin embedded human lung cancer tissue using CD163 antibody (2.5 ug/ml)

Western blot analysis of rat lung tissue using anti-CD163 (dilution of primary antibody at 1:500)
Quick Database Links
Documents Download
Request a Document
Protocol Information
Filter by Applications
Filter by Species
SP Dai, CC Yang, Y Chin, WH Sun TDAG8-mediated distinct signaling pathways modulate the early and late phases of neuropathic pain iScience, (2024)
Applications
Reactivity
Mengxuan Li,Nan Che,Xingzhe Liu,Yanhua Xuan,Yu Jin Dauricine regulates prostate cancer progression by inhibiting PI3K/AKT-dependent M2 polarization of macrophages Biochemical Pharmacology, 217, 115838 (2023)
Saba Ahangaran, Arash Pourgholaminejad, Rahim Nosrati, Parvin Babaei TLR4 inhibition attenuates facilitatory effects of JQ1 on learning & memory via polarization of microglia, and BDNF expression in Alzheimer's disease model Behav Brain Res, 499, 115919 (2026)
Applications
Reactivity
Chen-Roetling, Jing et al. Haptoglobin increases the vulnerability of CD163-expressing neurons to hemoglobin J Neurochem, 139, 586-595 (2016)
Jie Gong et al. Dauricine Inhibits Macrophages M2 Polarization and Regulates the Progression and Ferroptosis via HCK/IDO1 in Urinary Bladder Cancer Food Sci Nutr, 13(12), e71341 (2025)
Applications
Reactivity
Mertens, Barbara et al. Investigation of tumor-tumor interactions in a double human cervical carcinoma xenograft model in nude mice Oncotarget, 9, 21978-22000 (2018)
de Vries, M. R. et al. Blockade of vascular endothelial growth factor receptor 2 inhibits intraplaque haemorrhage by normalization of plaque neovessels J Intern Med, 285, 59-74 (2019)
Heindryckx, Femke et al. Inhibition of the placental growth factor decreases burden of cholangiocarcinoma and hepatocellular carcinoma in a transgenic mouse model Eur J Gastroenterol Hepatol, 24, 1020-1032 (2012)
Koronyo, Yosef et al. Therapeutic effects of glatiramer acetate and grafted CD115⁺ monocytes in a mouse model of Alzheimer's disease Brain, 138, 2399-2422 (2015)
Gibson, D. L. et al. Maternal exposure to fish oil primes offspring to harbor intestinal pathobionts associated with altered immune cell balance Gut Microbes, 6, 24-32 (2015)
Koronyo-Hamaoui, Maya et al. Peripherally derived angiotensin converting enzyme-enhanced macrophages alleviate Alzheimer-related disease Brain, 143, 336-358 (2020)
CD163 antibody (orb13303)
Participating in our Biorbyt product reviews program enables you to support fellow scientists by sharing your firsthand experience with our products.
Login to Submit a Review